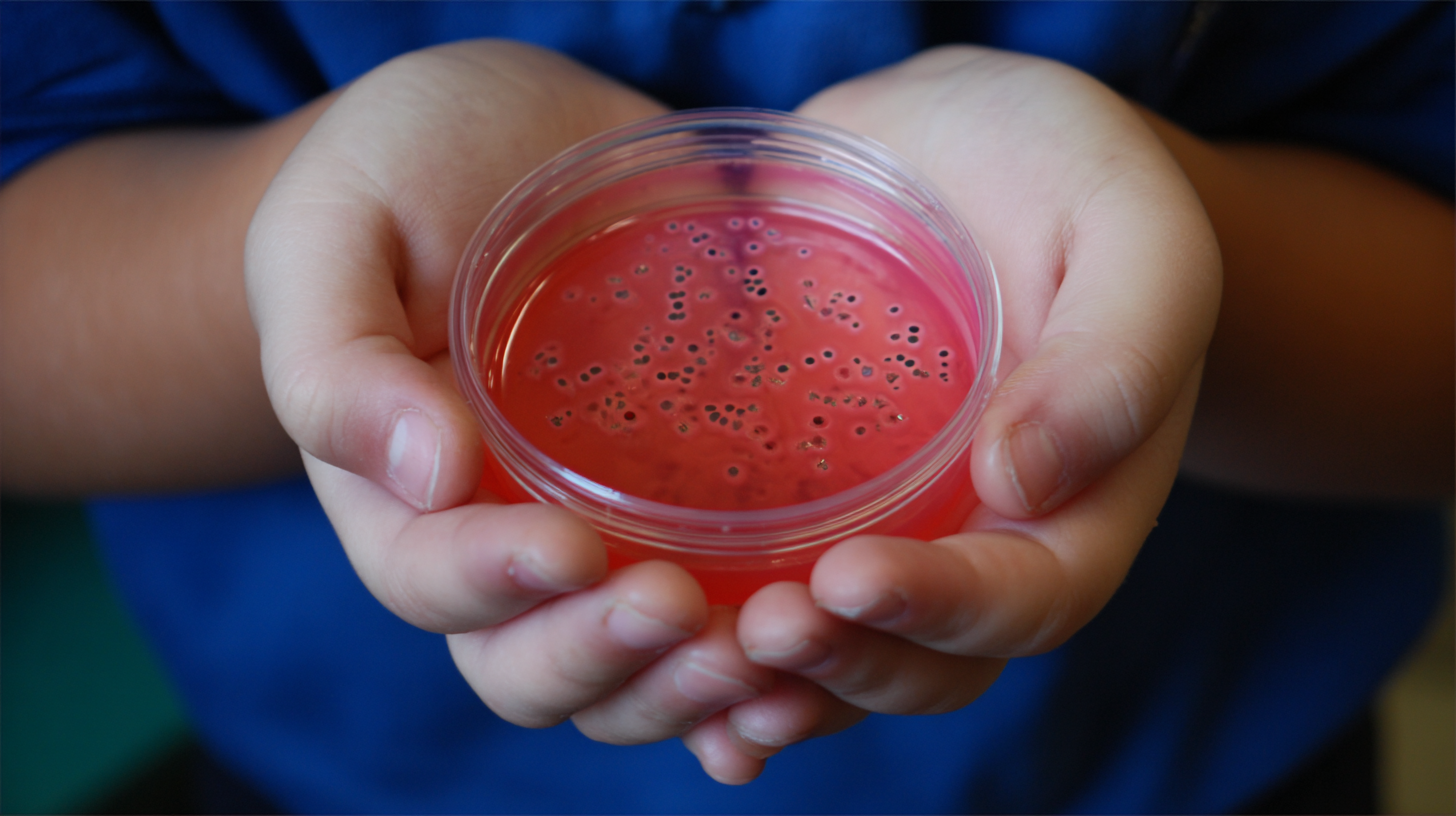

Education Policy & Reform

The Need to Lead with Purpose

What You Didn't Learn in School Part 1: Money Management

AI will disrupt but will the positive outweigh the negative?

Watch the Flowers Grow

Innovation by Invitation Only

Think Inside the Box

The Year We Rearranged the Deckchairs

OfSTED Unmasked

Innovation vs. Compliance: The Education Tightrope

The Tail Wagging the Dog: Unmasking the Gatekeepers of Education

Rewilding Education: From Monoculture to Thriving Rainforest

Collective Illusions Might Just Be Our Biggest Enemy

Inclusion: Stop Talking, Start Doing
The School Petri Dish: Breeding Brilliant Minds, Not Obedient Drones

Beyond the Factory: It's Time to Rebuild Education From the Ground Up
FAQs
Find answers to frequently asked questions about our blog, including how to subscribe, comment, or share posts.
The easiest way is to subscribe to our newsletter here and every new article will land in your inbox before anyone else sees it!
We have a number of partnership options available, including an option to sponsor our content (podcasts/newsletters). Check out our Partnerships page
Pop us a message via our Contact Form and we can look at how it might align with our content.
We have seasons of publishing - that’s the honest answer! We aim to do 2-3 newsletters per month when time permits, but we always push content out via our socials so check out those links and subscribe!
You sure can! We sometimes publish guest blogs like this one. If you want to feature, drop a message in our Contact Form and we can chat it through.
Stay Up To Date By Subscribing
The best way to never miss our content is to join our mailing list - simples!

